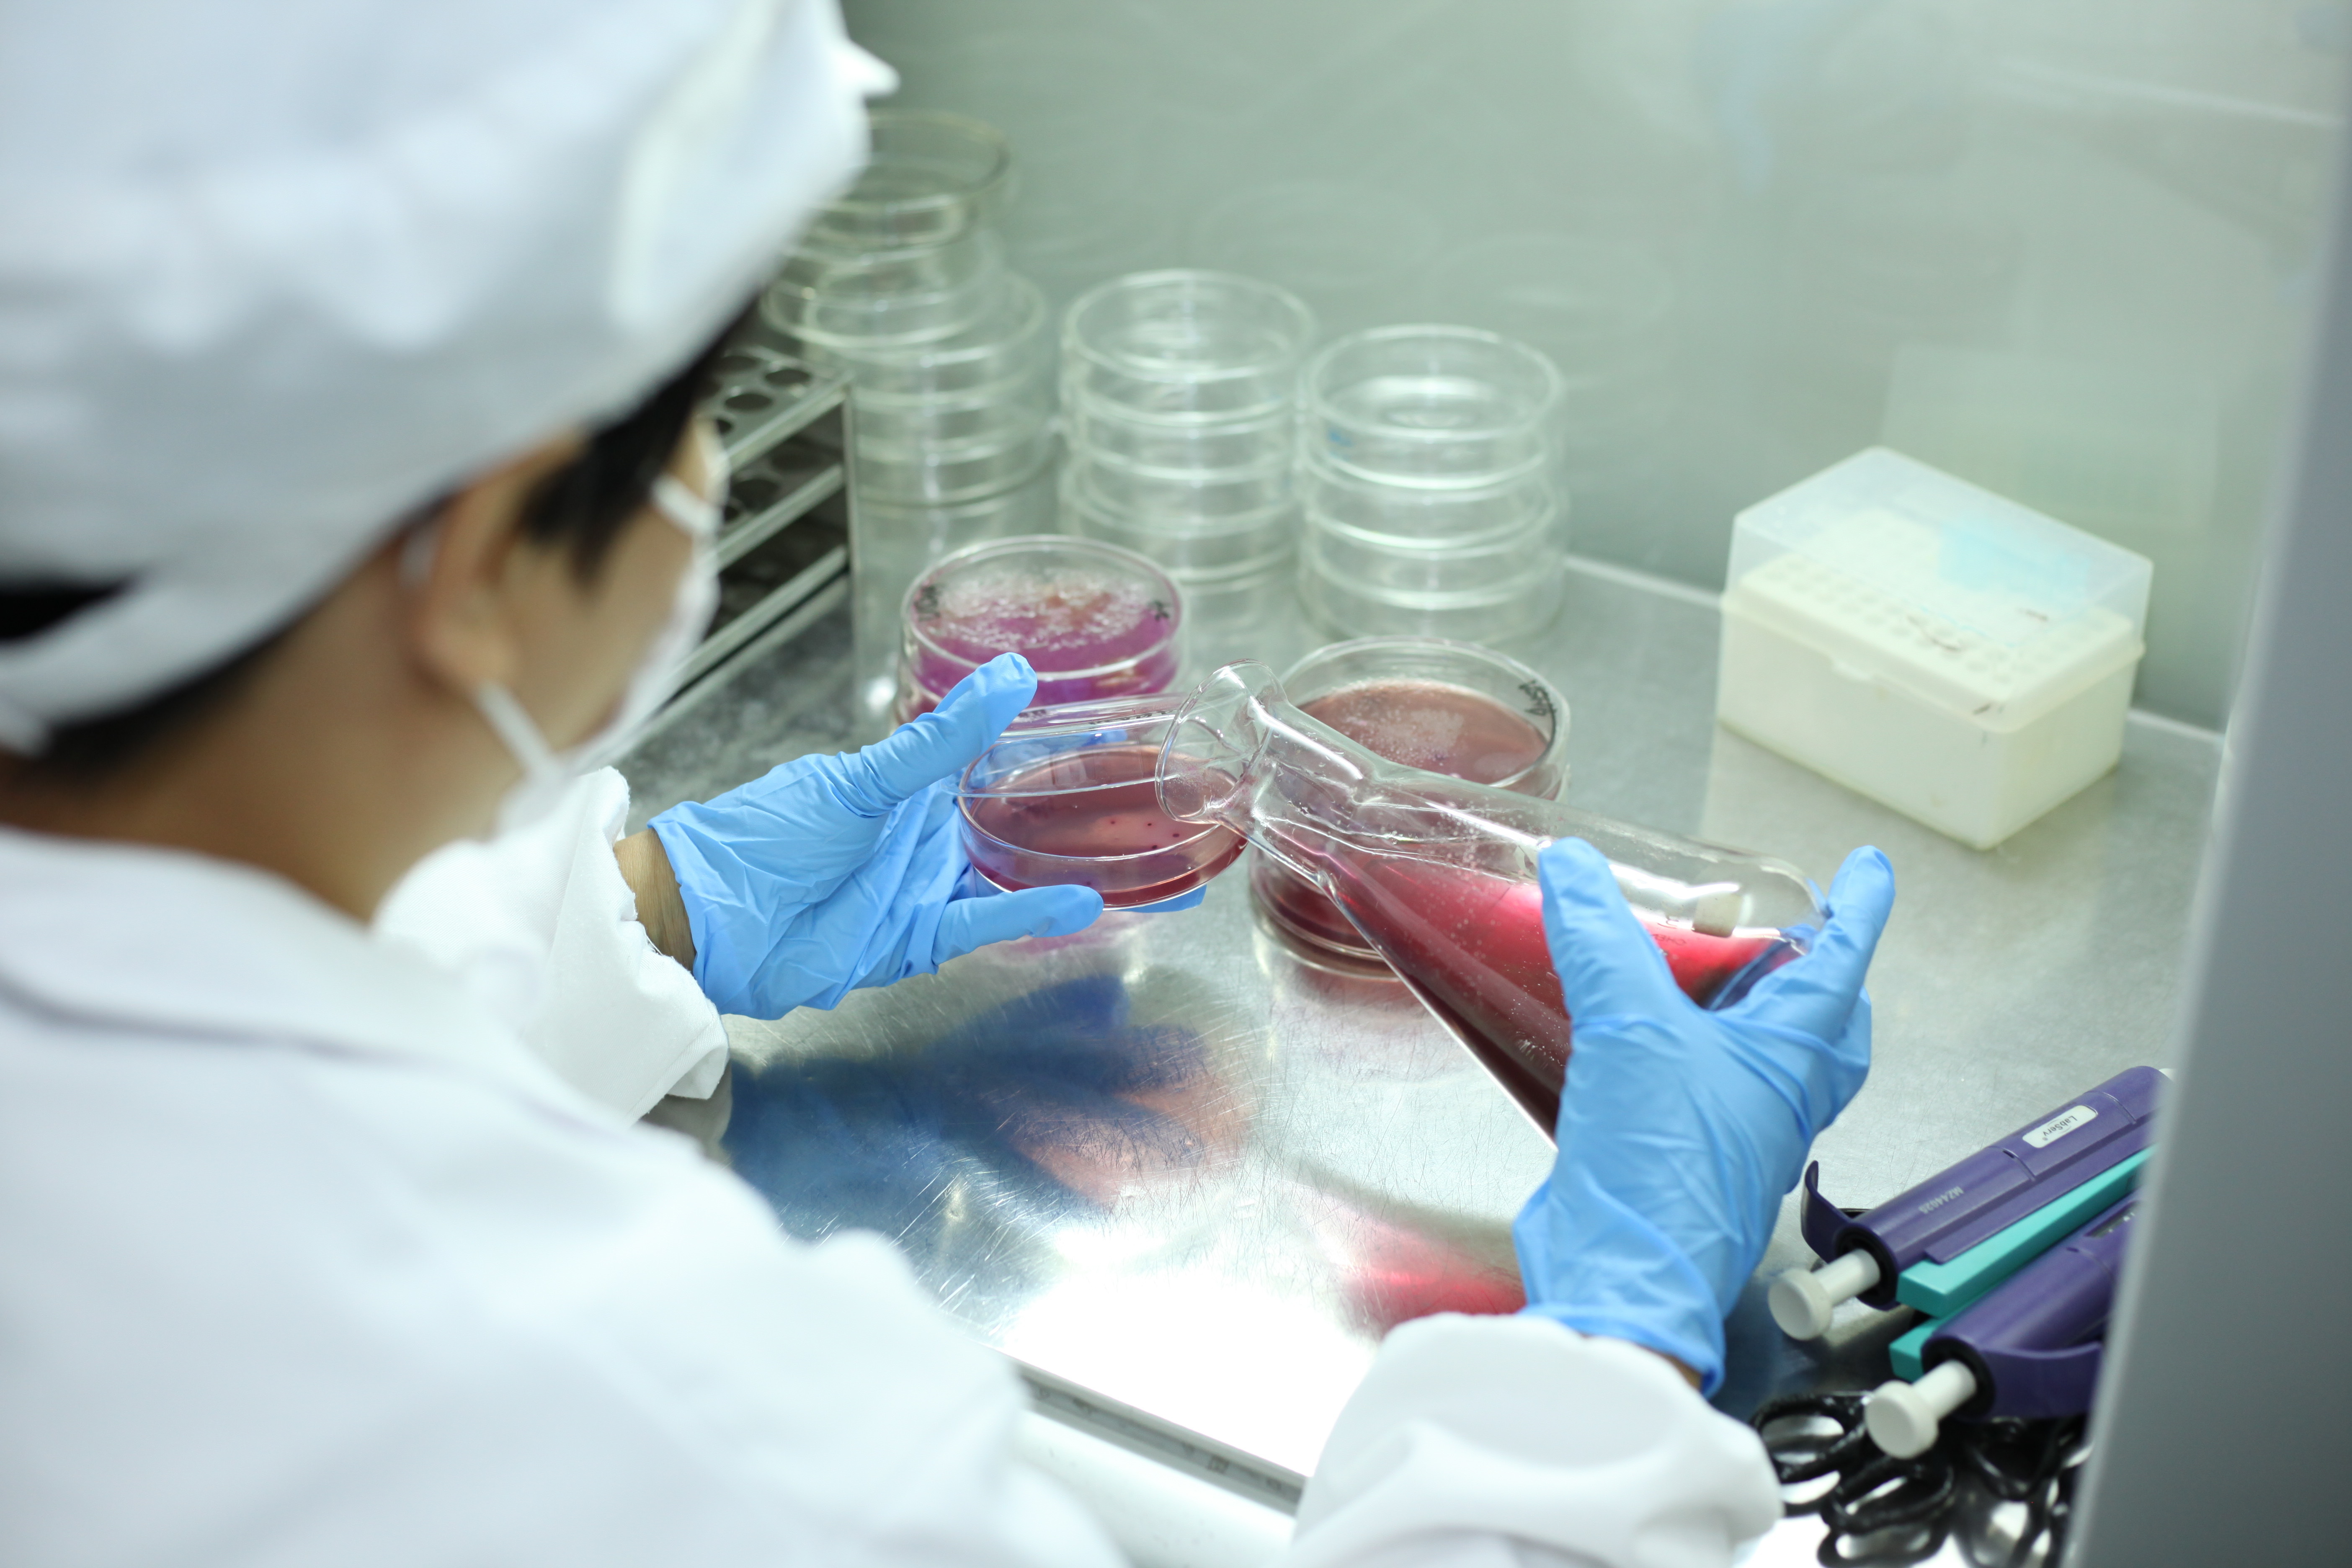
京博控股集团:以健康管理奏响职场奋进乐章

在国家卫健委联合多部门启动“体重管理年”三年行动之际,山东京博控股集团有限公司(以下简称:京博)以十年深耕健康管理的实践经验,交出了一份职工健康管理的亮眼答卷。从全员体质合格率85%跃升至99%,从健康体检到心理关怀,这家企业用系统性创新实践,为“健康中国行动”提供了极具参考价值的实践案例。

十年磨一剑:健康管理从理念到体系化
自2015年起,京博就积极投身健康管理事业,陆续推出健康体重管理、禁烟禁酒等特色制度,构建覆盖全员、全方位的健康管理体系。自2008年起至今,企业累计投入超3300万元用于员工体检,通过个性化套餐设计,有效防控肥胖、“三高”等慢性病风险。数据显示,员工体质健康合格率提升14个百分点,从85%提升至99%印证了健康管理的显著成效。

八维一体:打造职场健康生态圈
企业创新提出“八维一体”大健康管理体系,将健康制度、保障、服务、心理、运动等八大模块有机融合。在硬件层面,建成员工健身中心、游泳馆、篮球场等10余处类运动场馆,组建六大文化社团及八大运动兴趣小组;在软性服务上,开创“兼职健身教练团”开展科学指导,年度线上运动打卡突破百万人次,让健康生活成为职场新风尚。


精准关怀:从身体到心理的全周期守护
针对职场心理健康痛点,京博设立24小时心理咨询热线,为女性、驻外员工等特殊群体定制心理服务,覆盖率达100%。通过心理讲座、沙龙等多样化活动,构建起常态化心里健康服务网络。在食品安全领域,企业设立高标准食品安全检测室,通过18大类食品59项检测体系,从源头确保员工用餐饮水安全。同时,企业倡导员工科学合理饮食,推出低盐高纤健康餐,引导员工养成健康生活方式。

标杆引领:员工幸福指数与企业高质量发展同频共振
十年探索让京博荣获“全国健康企业建设优秀案例”“省级健康企业”“省职工生活幸福型企业”等多项殊荣。集团相关负责人表示,未来将深化“以员工心为心”理念,以国家“体重管理年”行动为契机,持续优化健康管理体系,推动员工幸福指数与企业高质量发展同频共振。

